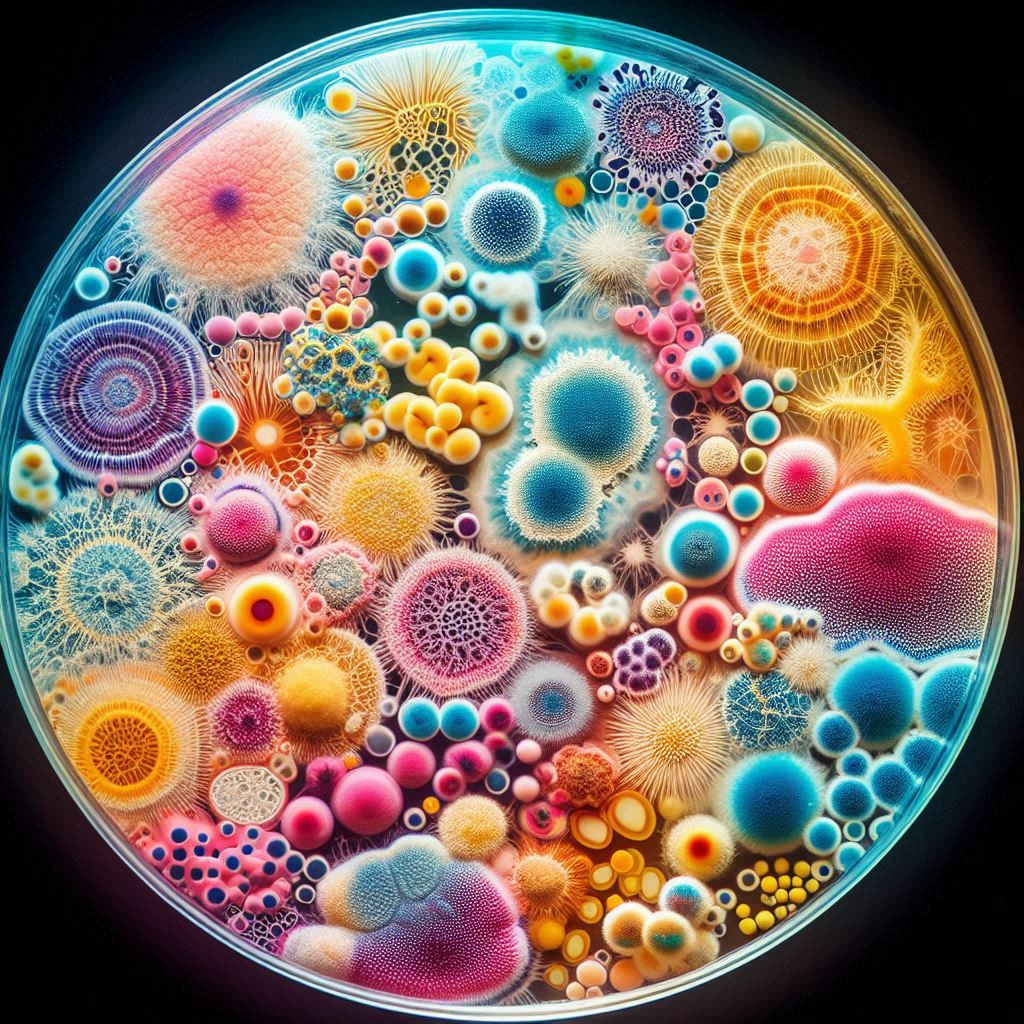

- Lecturer: Courtney Bullen
University of Guyana 2025/2026
Search results: 45
This course is designed to help students develop their skills in the critical analysis, practice and production of ethnography. Ethnography is understood both as a practice and as a product. As a practice, ethnography refers to the main methods of socio-cultural anthropology (participant observation). As a product, ethnography refers to the written, aural and visual creations that constitute the documentation and theorization of ethnographic practice.
This course will be most useful to students who wish to build basic skills in socio-cultural anthropology and archaeology. Students will read ethnographies and monographs, learn about how anthropological theory informs these works, and receive an introduction to the practice of ethnography through local supervised field projects
- Lecturer: Louisa Daggers
- Lecturer: Kayla De Freitas
- Lecturer: Kumar Mahabir
- Lecturer: Trevon Baird
- Lecturer: Phillip Da Silva
- Lecturer: Ferial Pestano
- Lecturer: Phillip Da Silva
- Lecturer: Lakhnarayan Bhagarathi
In this course, the student will be introduced to theoretical concepts of normal human growth and development across the lifespan following a bio-psycho-social perspective. Learning and observation of the many factors that contribute to the development of the human being over the entire lifespan both from the physiological and psychological point of view through a series of presentation, field visit and practical hands-on.
- Lecturer: Isha Urlin
- Lecturer: Lacram Kokil
- Lecturer: Rajendra Persaud
- Lecturer: Andrew Hicks
FACULTY OF EDUCATION & HUMANITIES
DEPARTMENT OF FOUNDATION AND EDUCATION MANAGEMENT
COURSE OUTLINE
COURSE NUMBER: EAD 3100/3200
COURSE NAME: Administration & Teaching Practicum III/ Administration & Teaching Practicum IV
NUMBER OF CREDITS: Two (2) EXEMPTIONS: Nil PRE & Co- REQUISITES: Nil INDICATION OF FOLLOW-ON COURSES: EAD 5109/5209
COURSE DESCRIPTION
This course is largely an outgrowth of courses on the content and methodology of teaching at the Primary and Secondary levels and the fundamentals of school administration. It is designed to offer supervision on the job to participants with responsibilities in teaching administration and supervision in the school systems. Its major aim is to improve teaching, instructional supervision and administrative practices. Supervision will focus mainly on teaching and instructional supervision with some emphasis on personal management and general administrative duties.
STUDENT LEARNING OUTCOMES
This course is designed to enable participants to:
· Improve their competence and proficiency in the teaching at the primary and/or secondary level
· Acquire an improved understanding of the content and methodology of teaching at the primary and/or secondary level
· Demonstrate instructional competence and supervision of curriculum and instruction
· Deal more effectively and efficiently with staffing and human relations in the general area of personnel management in their schools
· Improve their administrative practices
N.B. These objectives may be modified to suit the varying needs of the participants depending on whether their responsibilities lie mainly at the primary or secondary level or involve supervision at both levels.
COURSE REQUIREMENT
Each participant will be required to teach. Education Officers must give demonstration lessons.
Each participant will be required to keep a Journal of Teaching and Administration which will provide a record of activities undertaken on the job.
JOURNAL – COVERAGE/FOCUS
SEMESTER I
· Description/location of School
· Philosophy/ Pledge
· Aims/goals/objectives – medium and long term
· Special characteristics of school plant,e.g., calendar of activities, pledge, song etc
· Special characteristics of personnel/ issues and concerns
· Mentoring services provided
· Standard operational procedures, effects on management of school
· Problems and their causes/ solutions
· Conflict resolution & prevention
· Possible solutions/ suggestions for improving school plant
· Staff development sessions: evaluation and follow up activities
· Modes of supervision, e.g., clinical etc./ benefits to be derived
· PTA meetings – Impact on school development/improvement
· General staff meetings and follow up
· Relationships – teacher/teacher, pupil/teacher, pupil/pupil
SEMESTER II
Each participant is required to keep a Journal of Teaching and Administration which will provide a record of activities undertaken on the Job. The Journal should include:
· An introduction setting out the context of the organization
· Lesson plans and evaluation (where applicable)
· Records of Staff Development activities
· Records of Staff meetings and matters related to personnel management
· Details regarding resources allocation (where applicable)
· Documentation of P.T.A activities/meetings and general efforts to promote better School-Community relationship
· Administrative activities related to the overall management of the school
METHODS OF TEACHING
Largely individual supervision, group discussion
WEIGHTING OF ASSESSMENT
Participants will be visited for supervision on the job for about three (3) hours per semester in the first year of the degree programme.
Assessment for the Practical aspect will be worth 60% of the total grade, weighted as follows:
- Teaching 20%
- General school management/supervision/level 40%
The Journal will be graded and will be worth 40% of the total grade
Participants will be required to make submissions at various points in the academic year.
Responsibility of Student: By the middle of the first Semester it is the responsibility of the student to report to the Head of Department/ Coordinator if he or she was not supervised by the designated Supervisor.
- Lecturer: Collis Nicholson
- Lecturer: Tamika Jeffrey


- Lecturer: Michael Augustus
- Lecturer: Alanka Babb
- Lecturer: Akeshia Benjamin
- Lecturer: Troy Brown
- Lecturer: Tamashwar Budhoo
- Lecturer: Savitree Budram
- Lecturer: Shellanne Craigwell
- Lecturer: Nicole Duff
- Lecturer: Volda Elliott
- Lecturer: Mohandatt Goolsarran
- Lecturer: Melissa Gordon
- Lecturer: Deochand Jaiprashad
- Lecturer: Rosemaree Lester-Hutson
- Lecturer: Kara Lord
- Lecturer: Shawn Mc Bean
- Lecturer: Amelia Persaud
- Lecturer: Davin Persaud
- Lecturer: Natoya Ross-DeSantos
- Lecturer: Riaz Rupnarain
- Lecturer: Savitree Budram
- Lecturer: Mark Lyte
- Lecturer: Maureen Bynoe
- Lecturer: Maureen Bynoe

Adult Learning in A Digital Age
This course confidently explores the vital contributions of psychology to our understanding of adolescent growth and development. It provides a robust introduction to the teaching and learning process, with a strong focus on the specific needs of adolescents. We will thoroughly examine the pivotal role of teachers and educators, emphasizing effective methods and techniques that significantly enhance teaching performance and foster student learning. Furthermore, this course will tackle strategies for addressing adolescent challenges head-on, and will offer comprehensive guidance on identifying and diagnosing adolescents with special needs, while also cultivating supportive relationships to aid their development.
- Lecturer: Volda Elliott


This course is designed to provide students with an opportunity to apply their knowledge gained
in the Research Methods in Education course. It brings to students’ understanding the need and
importance of conducting a proposal prior to conducting research. The research proposal writing is
designed to provide each student with a step-by-step guide to writing a successful research proposal.
This course provides students with details and concepts to apply, as they conceptualize, design, and write
their research proposal in consultation with their assigned supervisor. The proposal consists of the first
three chapters: introduction, literature review, and the methodology chapters of the research.
The participants will be engaged in discovering and exploring their research interests, reviewing research
orientations, critiquing previously conducted research, and writing a proposal with the step-by-step
guidance of their supervisor.
- Lecturer: Imran Ally

Dear Teachers,
Welcome to our course, Introduction to Literacy Studies! I am delighted to have you join us as we embark on this journey to explore the fascinating world of reading theories and instructional strategies. My name is Ayana Williams, and I will be your lecturer for this course.
Course Description:
In this course, we will delve into the critical debates surrounding reading instruction, examining various methodologies and their impact on literacy development. We will explore how different reading theories shape literacy skills, improve comprehension, and inspire a lifelong love for reading. Additionally, we will compare strategies and content approaches to reading comprehension instruction, evaluating their effectiveness and potential benefits and drawbacks.
Through a combination of theoretical exploration and practical application, you will gain a comprehensive understanding of the science of reading and how to integrate diverse approaches into your teaching practices. Our goal is to equip you with the knowledge and skills needed to make informed decisions about your literacy teaching strategies, ultimately enhancing the reading outcomes for your learners.
I encourage you to actively participate in discussions, share your experiences, and engage with your peers as we navigate this course together. Your insights and contributions will be invaluable in creating a rich and collaborative learning environment.
I look forward to working with each of you and supporting you on this exciting journey. Let’s make this a rewarding and enriching experience for all.
Warm regards,
Ayana.
- Lecturer: Ayana Williams

Welcome to ESE3102: Early Literacy for Children with Special Needs This course is designed to equip you with the knowledge, skills, and strategies needed to support literacy development in young learners with diverse needs. Together, we will explore foundational theories of literacy, evidence-based practices for teaching reading and writing, and the use of assistive technology to promote access and engagement.
By the end of the course, you will be able to:
design effective literacy instruction for children with disabilities,
apply strategies to build phonological awareness, reading comprehension, and writing skills,
use assessment tools to monitor literacy growth,
and develop individualized intervention plans.
You will also learn to collaborate with families, communities, and professionals to foster inclusive literacy environments.
Through interactive lectures, discussions, and hands-on projects, this course will prepare you to become a confident, reflective educator who can make a meaningful difference in the literacy journeys of children with special needs.
Class Time: Tuesdays @ 6:30 pm
- Lecturer: Readonna Howell-Rogers

— LAW 2107 —
Jurisprudence
(& Caribbean Legal Theory)
Level: LL.B. Year 2, Semester 1 · Credits: 3 · Duration: 11 weeks
Class time: Thursdays, 18:15–21:10 (online)
Zoom: https://zoom.us/j/91546923160?pwd=b6XKkbjR43aaIO2iS6XrTmeqVZFAM2.1
Contact & Office Hours (Prof. Abel):
- Message via Moodle anytime (please allow up to 36 hours Mon–Thu; messages Fri–Sun answered on Monday; longer during public holidays).
- Virtual Office: Wednesdays, 08:00–10:00 (drop-in via the Zoom link).
Course Aim & Rationale
This course examines the origins, nature, and purpose of law across Western, Eastern, African, and Caribbean traditions, with a particular focus on the Commonwealth Caribbean and Guyana. It weaves together the “canon” of jurisprudence (Western, Eastern, and Ancient traditions) with Caribbean and Guyanese post-colonial contributions, showing both continuity and contestation.
The goal is to inspire our law students to contribute to a shared regional and national jurisprudential consensus. This will be achieved by fostering an environment that promotes strategic, critical and analytical thinking, problem-solving, and legal skills. Students will learn to move beyond simplistic approaches to real-world issues, viewing jurisprudence as a dynamic toolkit for nation-building, informed by historical and cultural foundations.
You will be encouraged to think beyond simple “either/or” positions and to contribute thoughtfully to a regional and national jurisprudential conversation grounded in shared values, history, and culture.
We therefore treat jurisprudence not as abstract speculation, but as a practical toolkit for legal reasoning, advocacy, judging, and policy.
Core Questions
We will return to these throughout the semester:
- Where does law come from?
- What is the nature, function, and purpose of law?
- Why does law matter to societies in general?
- What is the law’s significance in Western, Eastern, and Commonwealth Caribbean contexts?
- What is the relationship between law and morals?
- What is a legal obligation?
- How do legal rules and principles work, and how do judges decide cases?
These questions include critical engagement with the law–morality divide, justice, social order, and the role of legal systems in shaping ethical behaviour.
Answers to these questions will be sought by studying different methods of theoretical and practical legal reasoning as employed by leading theorists, ancient wisdom traditions, and Caribbean jurists and judicial decision-makers.
Learning Objectives
By the end of the course, you should be able to:
- Identify major sources of legal philosophy across Western, Eastern, African, and Caribbean traditions.
- Describe and critically compare key schools of jurisprudence.
- Explain central concepts in jurisprudential debates.
- Think independently and question the law with rigour and respect.
- Apply theoretical frameworks to concrete Caribbean legal problems.
- Appraise the relevance of these theories to the Commonwealth Caribbean and Guyana.
- Evaluate which approaches best address particular issues.
- Write clearly and critically about law, culture, and justice.
Teaching Team
Professor Justice (Ret.) Courtney Ashton Abel — Professor of Legal Practice, University of Guyana; former Justice of the Supreme Court of Belize; Barrister of the Inner Temple (Bencher). Practice and judicial experience across the Caribbean; research on J.O.F. Haynes; advocate for realistic and practice-oriented jurisprudence.
Professor Dawid Bunikowski — Philosopher of law based in Finland and Poland; works on legal philosophy, ethics, law & religion, and Arctic Indigenous rights; extensive international teaching and publications.
Mr. Chevy Devonish — Legal consultant and lecturer; experience in constitutional, administrative, and human rights law (Guyana AG Chambers); international arbitration exposure (Arnold & Porter, D.C.); writer on AI and the Caribbean.
How the Course Works
- One weekly online lecture (2 hours) led mainly by Profs. Abel and Bunikowski.
- One weekly tutorial (1 hour) led mainly by Mr. Devonish, focused on discussion, case analysis, and application.
- Moodle hosts slides, readings, worksheets, and prompts.
- Preparation: Complete the assigned readings and bring any questions to tutorials.
Study groups are encouraged for shared reading, debate, and practice writing.
Assessment
- Mid-term (Approximately Week 6): 30%
Group project on a leading jurist, tying biography, ideas, and impact to the course aims. - Tutorial presentation & participation: 10%
- Final Exam: 60%
Two essays chosen from at least four questions covering the full syllabus.
Course Content (Topics)
I. Orientation: What is Jurisprudence & its Sources?
- Jurisprudence as a toolkit for law in action.
- Ancient traditions: African Ma’at; Indian Dharma; Chinese Confucianism & Legalism; Greco-Roman thought.
- Western traditions: Judeo-Christian sources; Natural Law; Positivism.
- Law as culture, history, conflict, and community.
- Perspectives across Ancient, Traditional, Modern & Post-Modern thought.
- Caribbean voices: J.O.F. Haynes; Derek Walcott.
- Caribbean traditions: customary law, creolised/poetic/political jurisprudence.
II. Nature, Content & Relevance of Jurisprudence
- Methods of theorising law: linking theory, practice, and case law.
- Law as culture, community, and conflict in the Commonwealth Caribbean.
III. Natural Law
- Aristotle, Aquinas, Grotius, Fuller, Finnis.
- Caribbean contributions: C.L.R. James; Frantz Fanon; Lloyd Barnett; Simion McIntosh; Hilary Beckles.
- Applications in constitutional litigation.
IV. Positivism
- Bentham, Austin, Kelsen, Hart; the Hart–Fuller debate.
- Caribbean contributions: Telford Georges; Sir Hugh Wooding; Fenton Ramsahoye.
- Statutory and constitutional interpretation in the Caribbean.
V. The Historical School
- Savigny; organic development of law.
- Legal transplantation and colonial/post-colonial critique.
- Hybrid legal systems in the Caribbean.
VI. Marxism, Third World Approaches to International Law (TWAIL).
- Marx & Engels: law as superstructure; Althusser on ideology/state apparatus.
- Bhabha, Spivak, Fanon; Caribbean contributions: Shridath Ramphal; Mohamed Shahabuddeen.
- Responses to IMF/WTO conditionalities.
VII. Post-Colonial Theory Introduced & Explained
- Fanon; C.L.R. James; Édouard Glissant; Stuart Hall; Sylvia Wynter; George Lamming; Kamau Brathwaite; Derek Walcott; J.O.F. Haynes (judicial decolonisation); Simion McIntosh (constitutional emancipation); Mohamed Shahabuddeen (international law).
- Constitutional reform, sovereignty, rights discourse; CCJ and Guyanese case law.
VIII. Dworkin
- Response to positivism; law as integrity; principles vs. rules.
- Application to Caribbean rights jurisprudence.
IX. Legal Realism
- American Realists: Holmes, Llewellyn, Frank.
- Scandinavian Realists: Ross, Olivecrona.
- Prediction, institutions, and practice; Haynes’ judgments; CCJ decisions.
X. Kelsen
- Norms and the Grundnorm: legality after revolution.
- Grenada Revolution: constitutional crises and continuity/discontinuity.
XI. Postmodern & Contemporary Theories
- Structuralism; Critical Legal Studies; Feminist Jurisprudence; Critical Race Theory.
- Caribbean engagements: Walcott; Brathwaite; Glissant.
- Futures: pluralism, re-indigenisation, hybridity.
Required & Recommended Texts
Required
- J.W. Harris, Legal Philosophies (latest ed.), Butterworths.
- Michael Freeman, Lloyd’s Introduction to Jurisprudence (latest ed.), Sweet & Maxwell.
- James Penner, David Schiff & Richard Nobles, Jurisprudence and Legal Theory: Commentary and Materials (latest ed.), OUP.
Recommended (Caribbean & Comparative Focus)
- J.O.F. Haynes, Selected Writings on Law and Society.
- Simion McIntosh, Constitutional Reform in the Commonwealth Caribbean.
- Fenton Ramsahoye, The Development of Land Law in Guyana.
- Mohamed Shahabuddeen, Precedent in the World Court and essays on international law.
- Shridath Ramphal, Our Country, The Planet.
- Derek Walcott, The Antilles: Fragments of Epic Memory; Omeros.
- Édouard Glissant, Poetics of Relation.
- Key CCJ judgments: Maya Leaders Alliance v AG of Belize; AG v Joseph and Boyce (Barbados); leading Guyanese constitutional cases.
Expectations of Students
- Engage fully, read consistently, and think critically and independently.
- Meet deadlines; if challenges arise, communicate early.
- Come to tutorials ready to discuss, question, and apply ideas to cases.
Final Welcome
We look forward to a lively, rigorous, and relevant semester. Be curious, respectful, and bold in your thinking. Jurisprudence should change how you see the law—and how you will practice it.
Professor Justice (Ret.) Courtney Ashton Abel
- Lecturer: Courtney Abel
- Lecturer: Dawid Bunikowski
- Lecturer: Chevy Devonish
- Lecturer: Lakhnarayan Bhagarathi
- Lecturer: Lakhnarayan Bhagarathi
- Lecturer: Jamain Hatton
- Lecturer: Jamain Hatton
- Lecturer: Charlan Abrams
- Lecturer: Audrey Anderson
- Lecturer: Diana Seecharran
- Lecturer: Audrey Anderson
- Lecturer: Mickol Low Koon
- Lecturer: Angelina Autar